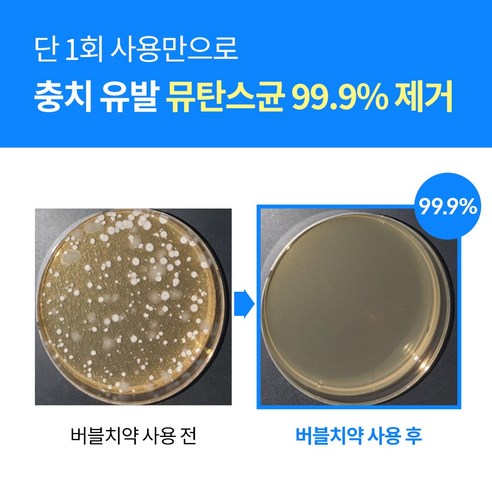

구강 건강은 우리 일상생활에 있어 매우 중요한 요소입니다. 특히, 충치와 구취 문제는 많은 사람들이 고민하는 부분이기도 합니다. 이럴 때 주목할 만한 제품이 등장했습니다. 바로 이스터14 S 노워터 에센셜오일 함유 충치균 박멸 버블 치약입니다. 본 제품은 일반인과 성인을 대상으로 하며, 충치 케어에 효과적이라는 점에서 특별한 가치를 지니고 있습니다.
충치 박멸의 강력한 파트너
이스터14 S 치약은 이름에서 알 수 있듯이, 일반적인 치약과는 다른 독특한 성격을 지니고 있습니다. 충치균을 효과적으로 박멸하는 데 도움을 줄 수 있는 에센셜 오일이 함유되어 있는 것이 특징입니다. 에센셜 오일은 각종 자연 유래 성분으로, 구강 내 미생물균의 균형을 조절하고, 깨끗한 입안을 유지할 수 있도록 돕습니다. 이 제품은 충치 예방을 위한 훌륭한 소스로 자리 잡고 있으며, 늘 바쁜 현대인에게 최적의 선택이 될 것입니다.
편리한 사용과 뛰어난 효율
이스터14 S 노워터 치약은 펌프형 용기 형태로 제작되어 있습니다. 이는 사용자에게 편리함을 제공합니다. 치약을 짜는 과정이 간편해, 손과 치약이 만나는 접촉 면을 최소화하여 위생적이며, 필요할 때 언제든지 간편하게 사용할 수 있습니다. 이러한 사용자 중심의 디자인은 바쁜 일상 속에서도 손쉽게 구강 건강을 유지할 수 있게 해 줍니다.
구취 제거의 새로운 패러다임
입냄새는 사회적 상황에서 많은 사람에게 불편함을 주는 요소입니다. 이스터14 S 치약은 그 자체로도 뛰어난 구취 제거 효과를 가지고 있어, 자신감을 갖고 날카로운 대화에 임할 수 있도록 돕습니다. 충치 예방뿐만 아니라, 상쾌한 감각을 통해 구강 위생을 더욱 향상시킵니다.
안전성과 신뢰성
또한, 이 제품은 의약외품으로 인증받아 그 안전성과 효과성에 있어 신뢰성을 보장합니다. 제조사인 케이엠제약(주)은 치약의 질감과 성분에 대한 높은 기준을 가지고 있어, 소비자들이 안심하고 사용할 수 있게 해 줍니다. 예를 들어, 저불소 및 무불소 치약으로서의 특징은 민감한 구강 상태를 가진 소비자들에게도 적합하여, 후한 평가를 받고 있습니다.
소비자 리뷰와 평점
총 2,161건의 평가가 이루어진 이스터14 S 노워터 치약은 평점 4.5/5라는 높은 점수를 기록하고 있습니다. 이는 제품의 실제 사용 경험이 소비자들에게 긍정적인 영향을 미쳤음을 의미합니다. 많은 사용자들이 이 제품을 통해 실질적인 효과를 보고 있으며, 특히 충치 예방과 구취 제거에 대한 만족도가 높습니다.
마치며
이스터14 S 노워터 에센셜오일 함유 충치균 박멸 버블 치약은 현대인의 구강 건강을 위한 믿음직한 선택으로 자리매김하고 있습니다. 충치 예방과 구취 제거라는 두 가지 문제를 동시에 해결할 수 있는 이 제품은 특히 바쁜 일상을 살아가는 성인들에게 안성맞춤입니다. 구강 건강을 위한 새로운 파트너를 찾고 있는 분들에게 이스터14 S 치약을 강력히 추천합니다.